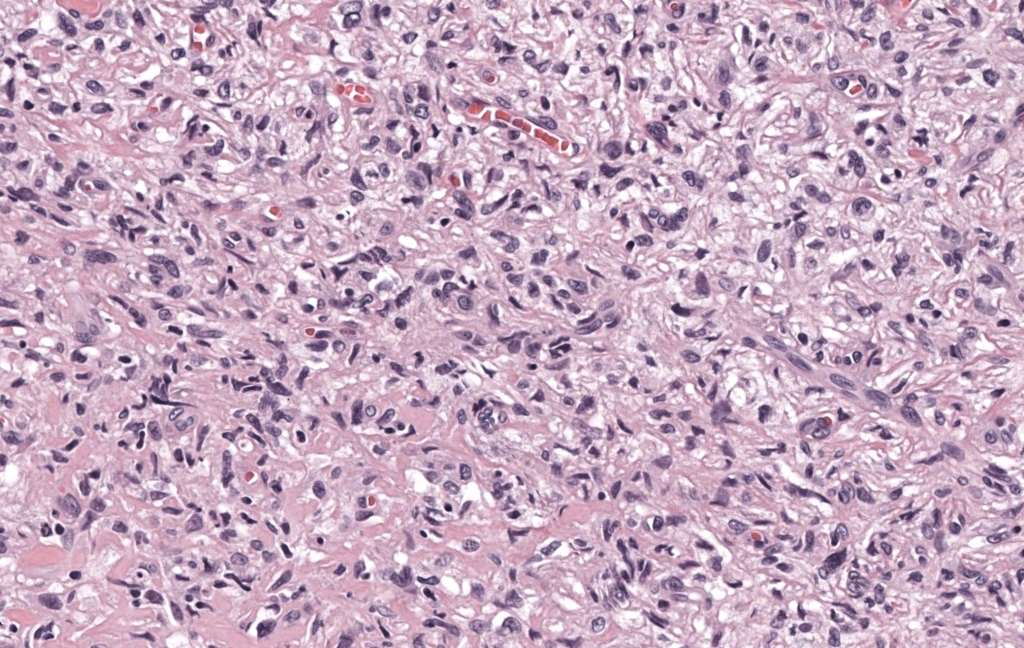

- Nombres: Dermatofibroma, Histiocitoma fibroso benigno cutáneo, Histiocitoma dérmico / fibrohistiocitoma cutáneo Myers 2025, Wan 2025.
- Historia
- Entidad descrita como histiocitoma fibroso benigno cutáneo desde la primera mitad del siglo XX; la denominación “dermatofibroma” se consolidó en la literatura de patología cutánea en la segunda mitad del siglo XX, revisada en profundidad por Zelger y cols. Zelger 2004.
- Se han ido describiendo variantes (atrofia, aneurismal, lipidizada, epiteloide, celular, etc.) a lo largo de las últimas décadas Zelger 1995, Iwata 2000, Alves 2014.
- Epidemiología
- Tumor cutáneo benigno MUY frecuente.
- Más habitual entre los 20–50 años, con claro predominio femenino (aprox. 2–4:1) Myers 2025, He 2025.
- Localización típica: extremidades inferiores (piernas) y superiores; tronco en menor medida Myers 2025, Estela 2014.
- Lesión habitualmente única. Formas múltiples o eruptivas son raras y pueden asociarse a inmunosupresión o VIH Wan 2025.
- En pediatría: menos frecuente; sólo ~5% de casos en <5 años en grandes series Berklite 2020.
- Códigos
- ICD-10-CM: se codifica como D23.x – Otros tumores benignos de piel, eligiendo el subcódigo según localización (cara D23.3, cuero cabelludo/cuello D23.4, tronco D23.5, extremidades superiores D23.6, extremidades inferiores D23.7, piel no especificada D23.9).
- ICD-11: 2F23.0 – Dermatofibroma, dentro de “Neoplasias cutáneas benignas”
- Checklist diagnóstico (rápido)
- Clínica imprescindible
- Nódulo/pápula firme de 2–10 mm, habitualmente en extremidades, de color pardo-rojizo o del color de la piel.
- Signo del hoyuelo positivo.
- Historia de crecimiento lento y estabilización; sin síntomas sistémicos.
- Dermatoscopia (caso típico)
-
- Red pigmentada periférica ± vasos delicados.
- Área central blanquecina/cicatricial o patrón compatible con alguna de las variantes descritas.
-
- Exámenes complementarios obligatorios sólo si:
-
- Lesión grande, profunda, recidivante o con atipia marcada → considerar imágenes (eco/RMN) y/o estudio molecular para descartar DFSP o sarcoma.
- Lesiones múltiples/eruptivas → cribado de LES, VIH, otras conectivopatías o neoplasias hematológicas.
-
- Clínica imprescindible